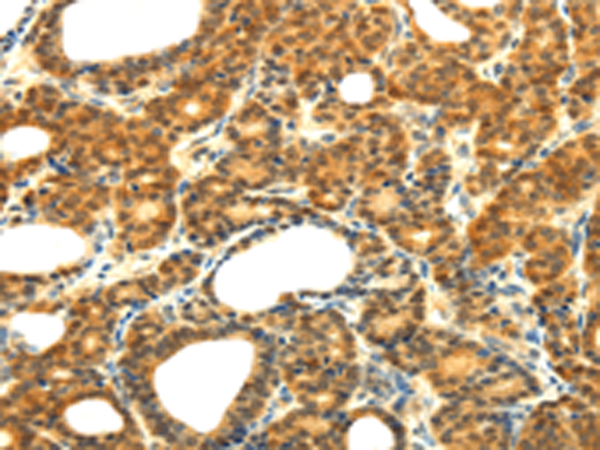
一抗

|
Background: |
The protein encoded by this gene contains a SH2 domain and a SOCS BOX domain. The protein thus belongs to the suppressor of cytokine signaling (SOCS) family, also known as STAT-induced STAT inhibitor (SSI) protein family. SOCS family members are known to be cytokine-inducible negative regulators of cytokine signaling. The specific function of this protein has not yet been determined. Two alternatively spliced transcript variants encoding an identical protein have been reported. |
|
Applications: |
ELISA, IHC |
|
Name of antibody: |
SOCS5 |
|
Immunogen: |
Fusion protein of human SOCS5 |
|
Full name: |
suppressor of cytokine signaling 5 |
|
Synonyms: |
CIS6; CISH6; Cish5; SOCS-5 |
|
SwissProt: |
O75159 |
|
ELISA Recommended dilution: |
2000-5000 |
|
IHC positive control: |
Human thyroid cancer and human ovarian cancer |
|
IHC Recommend dilution: |
25-100 |

 購物車
購物車 幫助
幫助
 021-54845833/15800441009
021-54845833/15800441009